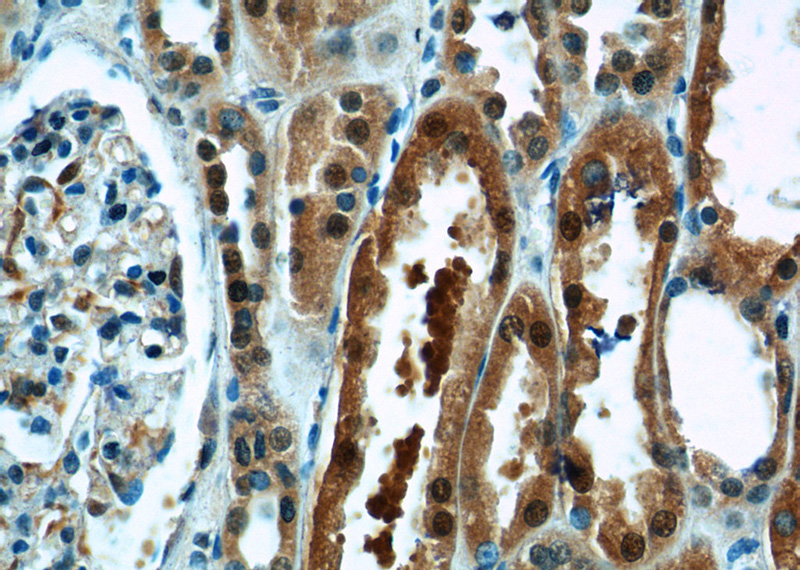
Immunohistochemistry of paraffin-embedded human kidney tissue slide using Catalog No:115887(TBX18 Antibody) at dilution of 1:50 (under 40x lens)

-
Product Name
TBX18 antibody
- Documents
-
Description
TBX18 Rabbit Polyclonal antibody. Positive IHC detected in human kidney tissue, human breast cancer tissue. Positive WB detected in HeLa cells, HEK-293 cells, human placenta tissue, mouse kidney tissue, rat kidney tissue. Observed molecular weight by Western-blot: 65-70 kDa
-
Tested applications
ELISA, WB, IHC
-
Species reactivity
Human, Mouse, Rat; other species not tested.
-
Alternative names
T box 18 antibody; T box protein 18 antibody; TBX18 antibody
- Immunogen
-
Isotype
Rabbit IgG
-
Preparation
This antibody was obtained by immunization of TBX18 recombinant protein (Accession Number: NM_001080508). Purification method: Antigen Affinity purified.
-
Clonality
Polyclonal
-
Formulation
PBS with 0.02% sodium azide and 50% glycerol pH 7.3.
-
Storage instructions
Store at -20℃. DO NOT ALIQUOT
-
Applications
Recommended Dilution:
WB: 1:500-1:5000
IHC: 1:20-1:200
-
Validations

HeLa cells were subjected to SDS PAGE followed by western blot with Catalog No:115887(TBX18 antibody) at dilution of 1:1000

Immunohistochemistry of paraffin-embedded human breast cancer tissue slide using Catalog No:115887(TBX18 Antibody) at dilution of 1:50 (under 40x lens)
Immunohistochemistry of paraffin-embedded human kidney tissue slide using Catalog No:115887(TBX18 Antibody) at dilution of 1:50 (under 40x lens)
-
Background
The T-box (Tbx) motif is present in a family of genes whose structural features and expression patterns support their involvement in developmental gene regulation. The Tbx gene family are largely conserved throughout metazoan evolution, and these genes code for putative transcription factors that share a uniquely defining DNA-binding domain. Tbx genes are a family of developmental regulators with more than 20 members recently identified in invertebrates and vertebrates. Mutations in Tbx genes are associated with the onset of several human diseases. Our understanding of functional mechanisms of Tbx products has come mainly from the prototypical T/Brachyury, which is a transcription activator. The Tbx genes constitute a family of transcriptional regulatory genes that are implicated in a variety of developmental processes ranging from the formation of germ layers to the organizational patterning of the central nervous system.This antibody specifically reacts with the 65kd TBX18 protein.
Related Products / Services
Please note: All products are "FOR RESEARCH USE ONLY AND ARE NOT INTENDED FOR DIAGNOSTIC OR THERAPEUTIC USE"
